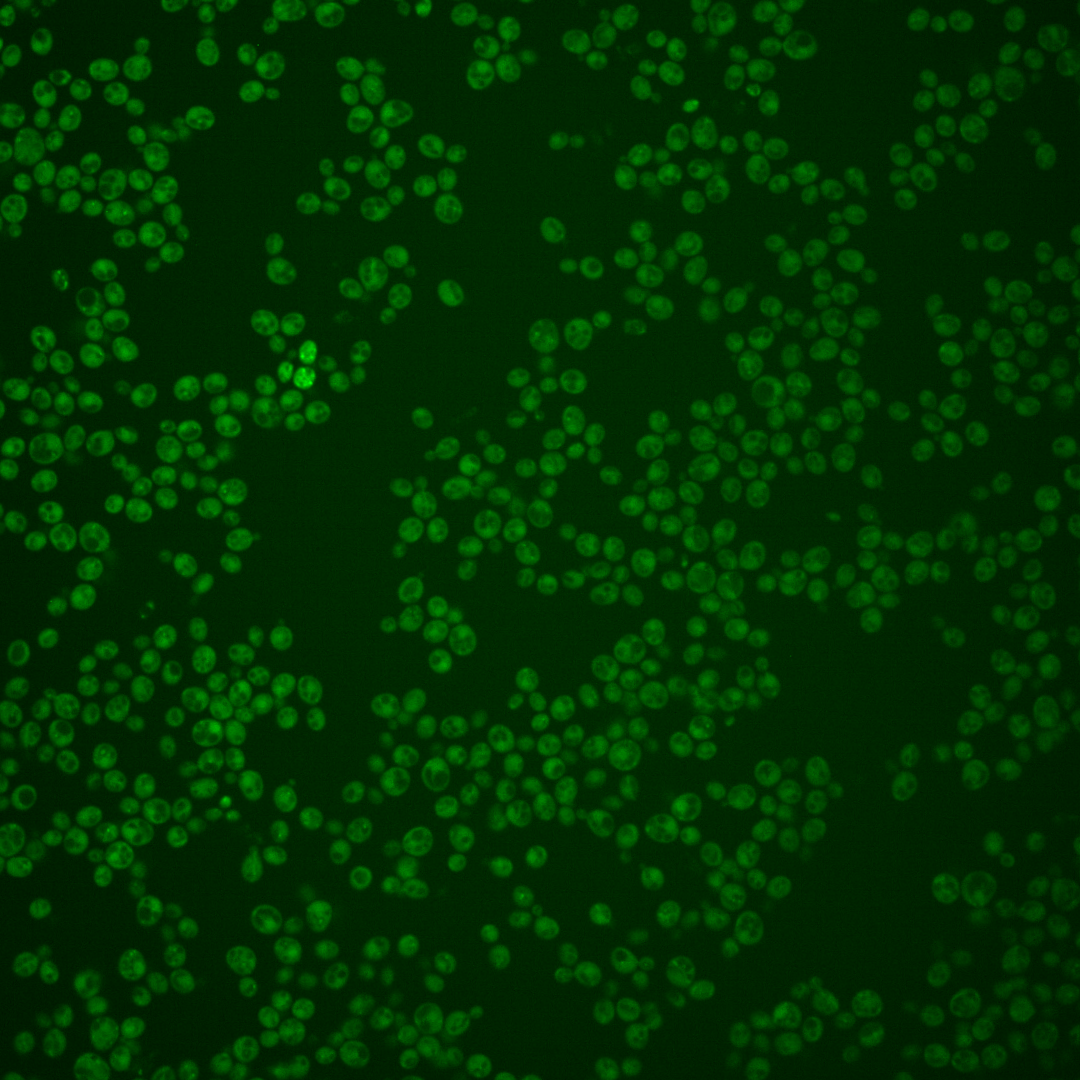
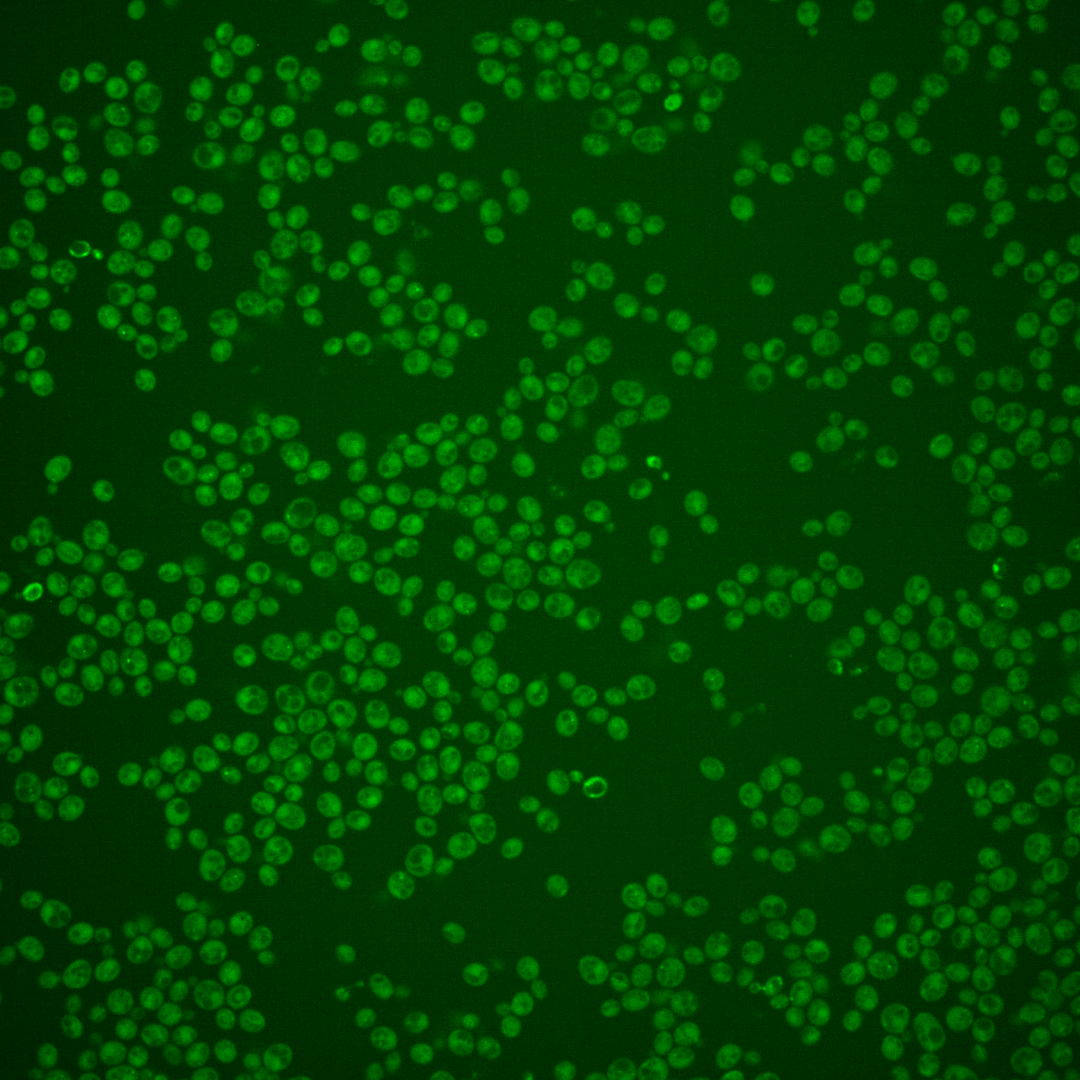
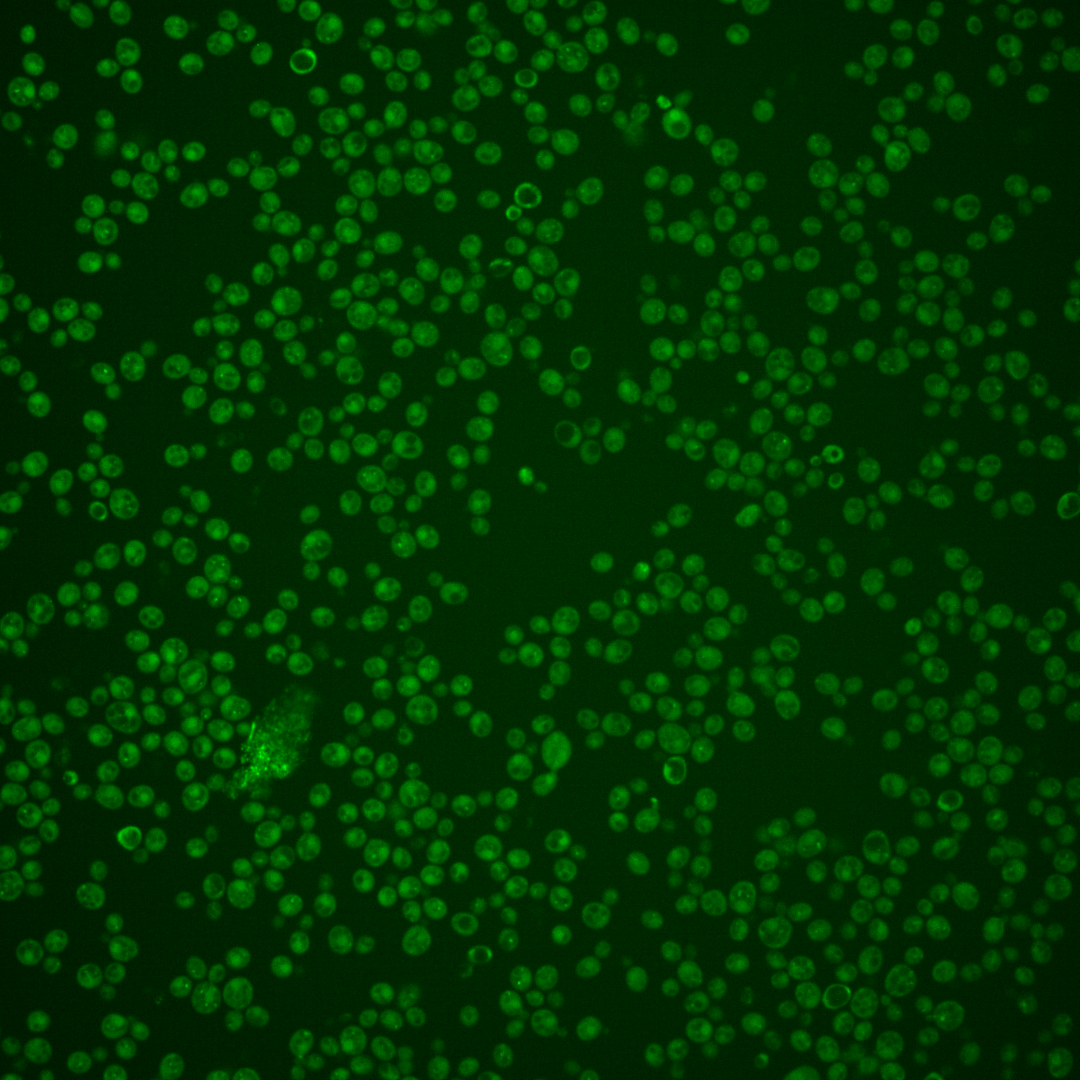

| Standard name | |
|---|---|
| Human Ortholog | |
| Description | Subunit of the BLOC-1 complex involved in endosomal maturation; interacts with Msb3p; null mutant is sensitive to drug inducing secretion of vacuolar cargo; green fluorescent protein (GFP)-fusion protein localizes to the cytoplasm |
Micrographs




















































































Sub-cellular Localization
Yeast GFP Assignment
Protein Abundance
Localization Change
External localization resources
| ensLOC | DeepLoc | |||||||||||||||||||||||
|---|---|---|---|---|---|---|---|---|---|---|---|---|---|---|---|---|---|---|---|---|---|---|---|---|
| Localization | WT1 | WT2 | WT3 | RAP60 | RAP140 | RAP220 | RAP300 | RAP380 | RAP460 | RAP540 | RAP620 | RAP700 | HU80 | HU120 | HU160 | rpd3Δ_1 | rpd3Δ_2 | rpd3Δ_3 | WT1 | WT2 | WT3 | AF100 | AF140 | AF180 |
| Cortical Patches | 1 | 1 | 1 | 0 | 1 | 0 | – | 0 | 0 | 0 | 0 | 0 | 0 | 0 | 1 | 0 | 0 | 0 | 14 | 7 | 3 | 1 | 0 | 3 |
| Bud | 9 | 7 | 17 | 13 | 8 | 17 | – | 21 | 14 | 27 | 17 | 17 | 0 | 1 | 0 | 0 | 1 | 0 | 6 | 1 | 1 | 1 | 3 | 4 |
| Bud Neck | 6 | 0 | 11 | 0 | 2 | 2 | – | 2 | 0 | 2 | 1 | 1 | 0 | 1 | 1 | 1 | 1 | 0 | 7 | 3 | 2 | 1 | 0 | 1 |
| Bud Site | 0 | 0 | 0 | 0 | 0 | 1 | – | 1 | 3 | 2 | 1 | 2 | 0 | 0 | 0 | 0 | 0 | 0 | – | – | – | – | – | – |
| Cell Periphery | 0 | 1 | 0 | 0 | 0 | 0 | – | 0 | 1 | 1 | 4 | 2 | 0 | 0 | 0 | 3 | 3 | 2 | 1 | 0 | 0 | 0 | 0 | 0 |
| Cytoplasm | 581 | 323 | 328 | 326 | 404 | 437 | – | 677 | 517 | 638 | 476 | 427 | 144 | 107 | 166 | 141 | 208 | 144 | 384 | 194 | 212 | 80 | 98 | 113 |
| Endoplasmic Reticulum | 4 | 5 | 2 | 0 | 1 | 1 | – | 0 | 0 | 0 | 1 | 0 | 2 | 2 | 0 | 8 | 11 | 11 | 1 | 0 | 3 | 1 | 1 | 2 |
| Endosome | 45 | 65 | 2 | 12 | 44 | 10 | – | 8 | 9 | 6 | 5 | 2 | 32 | 31 | 45 | 11 | 13 | 6 | 237 | 159 | 107 | 52 | 77 | 84 |
| Golgi | 1 | 0 | 0 | 0 | 0 | 0 | – | 0 | 0 | 0 | 0 | 0 | 0 | 0 | 2 | 2 | 2 | 0 | 1 | 3 | 0 | 0 | 3 | 6 |
| Mitochondria | 27 | 6 | 70 | 122 | 65 | 172 | – | 367 | 268 | 275 | 246 | 291 | 0 | 1 | 1 | 6 | 4 | 7 | 39 | 28 | 59 | 19 | 16 | 20 |
| Nucleus | 0 | 0 | 2 | 0 | 3 | 3 | – | 7 | 1 | 2 | 3 | 2 | 0 | 1 | 0 | 0 | 0 | 2 | 1 | 0 | 1 | 0 | 0 | 0 |
| Nuclear Periphery | 0 | 2 | 0 | 0 | 0 | 0 | – | 1 | 0 | 0 | 0 | 0 | 0 | 1 | 0 | 0 | 0 | 0 | 0 | 0 | 0 | 0 | 1 | 0 |
| Nucleolus | 0 | 1 | 0 | 0 | 1 | 0 | – | 2 | 0 | 0 | 1 | 1 | 0 | 0 | 0 | 0 | 1 | 1 | 0 | 0 | 0 | 0 | 1 | 0 |
| Peroxisomes | 0 | 1 | 0 | 4 | 6 | 8 | – | 1 | 2 | 4 | 1 | 0 | 0 | 1 | 0 | 0 | 0 | 0 | 0 | 0 | 0 | 0 | 0 | 0 |
| SpindlePole | 46 | 22 | 36 | 12 | 26 | 16 | – | 13 | 14 | 18 | 7 | 9 | 8 | 14 | 12 | 4 | 5 | 4 | 57 | 17 | 34 | 11 | 22 | 15 |
| Vac/Vac Membrane | 25 | 17 | 3 | 5 | 8 | 10 | – | 5 | 4 | 6 | 3 | 7 | 8 | 8 | 10 | 4 | 6 | 3 | 87 | 39 | 29 | 23 | 34 | 41 |
| Unique Cell Count | 709 | 419 | 420 | 409 | 505 | 548 | 859 | 661 | 773 | 606 | 592 | 179 | 156 | 226 | 158 | 227 | 161 | 865 | 465 | 480 | 202 | 269 | 299 | |
| Labelled Cell Count | 745 | 451 | 472 | 494 | 569 | 677 | 1105 | 833 | 981 | 766 | 761 | 194 | 168 | 238 | 180 | 255 | 180 | 865 | 465 | 480 | 202 | 269 | 299 | |
Yeast GFP Assignment
Protein Abundance
| Screen | WT1 | WT2 | WT3 | RAP60 | RAP140 | RAP220 | RAP300 | RAP380 | RAP460 | RAP540 | RAP620 | RAP700 | HU80 | HU120 | HU160 | rpd3Δ_1 | rpd3Δ_2 | rpd3Δ_3 | AF100 | AF140 | AF180 |
|---|---|---|---|---|---|---|---|---|---|---|---|---|---|---|---|---|---|---|---|---|---|
| Mean Cell GFP Intensity (1e-4) | 4.1 | 4.6 | 3.3 | 3.2 | 4.0 | 3.2 | – | 3.3 | 2.9 | 3.2 | 3.4 | 2.9 | 5.1 | 5.3 | 5.0 | 5.6 | 5.5 | 5.3 | 4.6 | 5.1 | 5.3 |
| Std Deviation (1e-4) | 0.4 | 0.8 | 0.7 | 1.2 | 1.4 | 0.9 | – | 1.2 | 1.1 | 0.9 | 6.4 | 0.6 | 1.1 | 1.4 | 0.9 | 1.4 | 1.2 | 1.4 | 1.1 | 1.3 | 1.4 |
| Intensity Change (Log2) | – | – | – | -0.05 | 0.26 | -0.06 | – | 0.0 | -0.21 | -0.07 | 0.04 | -0.19 | 0.62 | 0.66 | 0.59 | 0.74 | 0.73 | 0.67 | 0.48 | 0.61 | 0.68 |
Localization Change
| Localization | RAP60 | RAP140 | RAP220 | RAP300 | RAP380 | RAP460 | RAP540 | RAP620 | RAP700 | HU80 | HU120 | HU160 | rpd3Δ_1 | rpd3Δ_2 | rpd3Δ_3 |
|---|---|---|---|---|---|---|---|---|---|---|---|---|---|---|---|
| Actin | – | – | – | – | – | – | – | – | – | – | – | – | – | – | – |
| Bud | – | – | – | – | – | – | – | – | – | – | – | – | – | – | – |
| Bud Neck | – | – | – | – | – | – | – | – | – | – | – | – | – | – | – |
| Bud Site | – | – | – | – | – | – | – | – | – | – | – | – | – | – | – |
| Cell Periphery | – | – | – | – | – | – | – | – | – | – | – | – | – | – | – |
| Cyto | – | – | – | – | – | – | – | – | – | – | – | – | – | – | – |
| Endoplasmic Reticulum | – | – | – | – | – | – | – | – | – | – | – | – | – | – | – |
| Endosome | – | – | – | – | – | – | – | – | – | – | – | – | – | – | – |
| Golgi | – | – | – | – | – | – | – | – | – | – | – | – | – | – | – |
| Mitochondria | – | – | – | – | – | – | – | – | – | – | – | – | – | – | – |
| Nuclear Periphery | – | – | – | – | – | – | – | – | – | – | – | – | – | – | – |
| Nuc | – | – | – | – | – | – | – | – | – | – | – | – | – | – | – |
| Nucleolus | – | – | – | – | – | – | – | – | – | – | – | – | – | – | – |
| Peroxisomes | – | – | – | – | – | – | – | – | – | – | – | – | – | – | – |
| SpindlePole | – | – | – | – | – | – | – | – | – | – | – | – | – | – | – |
| Vac | – | – | – | – | – | – | – | – | – | – | – | – | – | – | – |
| Cortical Patches | – | – | – | – | – | – | – | – | – | – | – | – | – | – | – |
| Cytoplasm | – | – | – | – | – | – | – | – | – | – | – | – | – | – | – |
| Nucleus | – | – | – | – | – | – | – | – | – | – | – | – | – | – | – |
| Vacuole | – | – | – | – | – | – | – | – | – | – | – | – | – | – | – |
External localization resources
Images






























Protein Concentration and Protein Localization Data
| R1 | R2 | R3 | ||||||||||||||||
|---|---|---|---|---|---|---|---|---|---|---|---|---|---|---|---|---|---|---|
| G1 Pre-START | G1 Post-START | S/G2 | Metaphase | Anaphase | Telophase | G1 Pre-START | G1 Post-START | S/G2 | Metaphase | Anaphase | Telophase | G1 Pre-START | G1 Post-START | S/G2 | Metaphase | Anaphase | Telophase | |
| Concentration | 0.1903 | 0.64 | 0.4311 | 0.152 | 0.2746 | 0.4449 | -0.0991 | -0.0136 | 0.0383 | 0.184 | 0.6803 | -0.1221 | 0.918 | 1.3581 | 1.2632 | 1.5829 | 0.946 | 1.2171 |
| Actin | 0.009 | 0.0006 | 0.0004 | 0.0021 | 0.0001 | 0.0016 | 0.0161 | 0.0044 | 0.0119 | 0.0079 | 0.0007 | 0.0054 | 0.012 | 0.0006 | 0.0018 | 0.0001 | 0.0001 | 0.0013 |
| Bud | 0.0003 | 0.0051 | 0.0007 | 0.0004 | 0.0001 | 0.0021 | 0.0041 | 0.0032 | 0.0015 | 0.0005 | 0.0003 | 0.0004 | 0.0018 | 0.0009 | 0.0021 | 0.0002 | 0.0008 | 0.0002 |
| Bud Neck | 0.0006 | 0.0008 | 0.0005 | 0.0091 | 0.0002 | 0.002 | 0.0051 | 0.0022 | 0.0036 | 0.0004 | 0.0012 | 0.0096 | 0.0013 | 0.0004 | 0.0002 | 0.0002 | 0.0004 | 0.0033 |
| Bud Periphery | 0.0003 | 0.0018 | 0.0009 | 0.0003 | 0.0001 | 0.0021 | 0.0097 | 0.0055 | 0.0017 | 0.0007 | 0.0003 | 0.0009 | 0.0026 | 0.001 | 0.0022 | 0.0002 | 0.0009 | 0.0002 |
| Bud Site | 0.0007 | 0.0056 | 0.001 | 0.0017 | 0.0001 | 0.002 | 0.0174 | 0.0284 | 0.0137 | 0.0007 | 0.0016 | 0.0002 | 0.002 | 0.0026 | 0.0028 | 0.0001 | 0.0009 | 0.0002 |
| Cell Periphery | 0.0001 | 0.0002 | 0.0001 | 0.0001 | 0 | 0.0001 | 0.0006 | 0.0004 | 0.0005 | 0.0001 | 0.0002 | 0.0001 | 0.0003 | 0.0002 | 0.0001 | 0.0001 | 0.0001 | 0.0001 |
| Cytoplasm | 0.1035 | 0.1377 | 0.1354 | 0.0876 | 0.0675 | 0.132 | 0.0735 | 0.0956 | 0.0793 | 0.068 | 0.1449 | 0.1045 | 0.1294 | 0.1592 | 0.1571 | 0.1184 | 0.1541 | 0.1647 |
| Cytoplasmic Foci | 0.2337 | 0.2294 | 0.2706 | 0.3286 | 0.3539 | 0.3166 | 0.2231 | 0.2079 | 0.2767 | 0.2724 | 0.2344 | 0.2489 | 0.2202 | 0.2588 | 0.2202 | 0.194 | 0.2138 | 0.2782 |
| Eisosomes | 0.0001 | 0.0001 | 0.0001 | 0 | 0 | 0 | 0.0006 | 0.0001 | 0.0002 | 0.0001 | 0 | 0.0001 | 0.0002 | 0.0001 | 0.0001 | 0.0001 | 0 | 0.0001 |
| Endoplasmic Reticulum | 0.0036 | 0.0021 | 0.0024 | 0.0006 | 0.0005 | 0.002 | 0.0039 | 0.0017 | 0.0022 | 0.0023 | 0.0018 | 0.0016 | 0.003 | 0.0023 | 0.0039 | 0.0015 | 0.0027 | 0.0019 |
| Endosome | 0.2128 | 0.179 | 0.2031 | 0.2606 | 0.2939 | 0.192 | 0.1319 | 0.1347 | 0.1381 | 0.2379 | 0.2812 | 0.1281 | 0.2201 | 0.1747 | 0.1837 | 0.1994 | 0.296 | 0.1507 |
| Golgi | 0.0067 | 0.0056 | 0.0075 | 0.0106 | 0.0083 | 0.005 | 0.0105 | 0.0046 | 0.0093 | 0.0207 | 0.0151 | 0.0067 | 0.0053 | 0.0061 | 0.0068 | 0.0056 | 0.0064 | 0.0049 |
| Lipid Particles | 0.0214 | 0.0273 | 0.018 | 0.0046 | 0.0156 | 0.0173 | 0.0253 | 0.0179 | 0.0205 | 0.0249 | 0.0338 | 0.0205 | 0.0253 | 0.0112 | 0.012 | 0.008 | 0.0029 | 0.03 |
| Mitochondria | 0.0027 | 0.0013 | 0.0041 | 0.0011 | 0.0006 | 0.0013 | 0.0126 | 0.0023 | 0.005 | 0.0072 | 0.0033 | 0.0052 | 0.0032 | 0.0031 | 0.0027 | 0.0035 | 0.0029 | 0.0015 |
| None | 0.3693 | 0.3635 | 0.3165 | 0.2535 | 0.2335 | 0.2862 | 0.3994 | 0.4444 | 0.369 | 0.3072 | 0.238 | 0.4036 | 0.3371 | 0.3461 | 0.369 | 0.4435 | 0.2589 | 0.3281 |
| Nuclear Periphery | 0.0061 | 0.0017 | 0.0016 | 0.0008 | 0.0007 | 0.0019 | 0.0106 | 0.0018 | 0.0031 | 0.0071 | 0.0011 | 0.0024 | 0.0013 | 0.0016 | 0.0024 | 0.0011 | 0.0019 | 0.0014 |
| Nucleolus | 0.0006 | 0.0018 | 0.0008 | 0.0007 | 0.0002 | 0.0011 | 0.0032 | 0.0018 | 0.0014 | 0.0006 | 0.0014 | 0.0016 | 0.0013 | 0.0007 | 0.0006 | 0.0002 | 0.0004 | 0.0008 |
| Nucleus | 0.0036 | 0.0025 | 0.0017 | 0.0069 | 0.0006 | 0.0051 | 0.0056 | 0.0036 | 0.004 | 0.0037 | 0.0014 | 0.002 | 0.0022 | 0.0017 | 0.0014 | 0.0008 | 0.0026 | 0.0031 |
| Peroxisomes | 0.0085 | 0.0102 | 0.017 | 0.0079 | 0.0114 | 0.0163 | 0.0247 | 0.0116 | 0.039 | 0.0126 | 0.0105 | 0.0338 | 0.0046 | 0.0102 | 0.016 | 0.0081 | 0.0031 | 0.011 |
| Punctate Nuclear | 0.0037 | 0.0073 | 0.0038 | 0.0016 | 0.0035 | 0.0055 | 0.0076 | 0.0162 | 0.0096 | 0.0037 | 0.0025 | 0.0185 | 0.0022 | 0.0039 | 0.003 | 0.0009 | 0.0012 | 0.0097 |
| Vacuole | 0.0111 | 0.0152 | 0.0122 | 0.0196 | 0.0072 | 0.0065 | 0.0119 | 0.0105 | 0.0081 | 0.0167 | 0.0241 | 0.005 | 0.0229 | 0.0132 | 0.0099 | 0.0115 | 0.0423 | 0.0076 |
| Vacuole Periphery | 0.0014 | 0.0014 | 0.0017 | 0.0016 | 0.0022 | 0.0013 | 0.0026 | 0.0011 | 0.0015 | 0.0045 | 0.0024 | 0.001 | 0.0016 | 0.0014 | 0.002 | 0.0024 | 0.0076 | 0.0012 |
Sequencing Data
| R1 | R2 | |||||||||
|---|---|---|---|---|---|---|---|---|---|---|
| G1 Post-START | S/G2 | Metaphase | Anaphase | Telophase | G1 Post-START | S/G2 | Metaphase | Anaphase | Telophase | |
| Gene Expression | 19.4367 | 16.0386 | 15.8685 | 32.2378 | 13.5695 | 20.9202 | 20.2708 | 26.4508 | 37.1363 | 28.1389 |
| Translational Efficiency | 1.2276 | 1.2832 | 1.2756 | 0.8244 | 1.3444 | 1.1936 | 0.6123 | 0.9042 | 0.7584 | 0.8684 |
Hit Data
| Dataset | Hit |
|---|---|
| Protein Concentration | ✔ |
| Protein Localization | ✘ |
| Gene Expression | ✘ |
| Translational Efficiency | ✘ |
Endocytosis
| Temp | Actin Patch (Sac6-tdTomato) | Cortical Patch (Sla1-GFP) | Late Endosome (Snf7-GFP) | Vacuole (Vph1-GFP) |
|---|---|---|---|---|
| 37℃ | ||||
| RT |
Cell Cycle Omics
CYCLoPs (Cnl1-GFP)
| Gene / Allele | Actin Patch (Sac6-tdTomato) | Cortical Patch (Sla1-GFP) | Late Endosome (Snf7-GFP) | Vacuole (Sac6-tdTomato) |
|---|
| Gene | Images |
|---|
| Gene | Images |
|---|
Images are not yet available
Images are not yet available